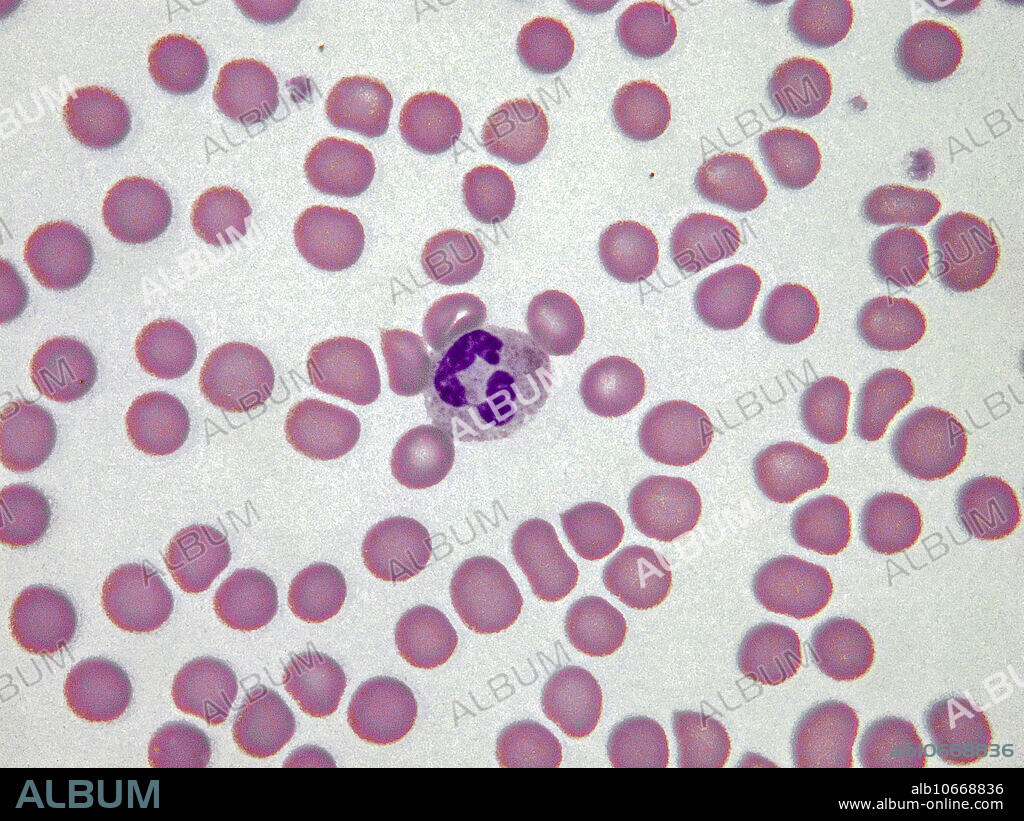
Pelger-Huet anomaly is a benign dominantly inherited defect of terminal neutrophil differentiation secondary to mutations in the lamin B receptor (LBR) gene. Some leukocytes appear as dumbbell-shaped bilobed nuclei (as shown here). Light micrograph, Wright-Giemsa stain. Magnification: 100x.

alb10668836
Pelger-Huet anomaly, LM
|
Add to another lightbox |
|
Add to another lightbox |



Buy this image.
Select the use:

Title: Pelger-Huet anomaly, LM
Caption: Pelger-Huet anomaly is a benign dominantly inherited defect of terminal neutrophil differentiation secondary to mutations in the lamin B receptor (LBR) gene. Some leukocytes appear as dumbbell-shaped bilobed nuclei (as shown here). Light micrograph, Wright-Giemsa stain. Magnification: 100x.
Credit: Album / Nature's Faces/Science Source
Releases: ? Model Release: No - ? Property Release: No
Rights questions?
Rights questions?
Image size: 3000 × 2250 px | 19.3 MB
Print size: 25.4 × 19.1 cm | 1181.1 × 885.8 in (300 dpi)
Keywords: ANOMALY • BLOOD • CELL • DEFECT • DIFFERENTIATION • DUMBELL-SHAPED • GIEMSA • HEREDITARY • HUET • INHERITED • LIGHT • LM • MICROGRAPH • MICROGRAPHY • MICROSCOPY • MUTATION • NEUTROPHIL • PELGER • PELGER-HUET • PHA • SANGUINE • STAIN • WRIGHT-GIEMSA


 Pinterest
Pinterest Twitter
Twitter Facebook
Facebook Copy link
Copy link Email
Email
